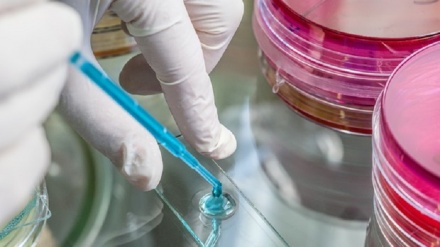

-

Diabete, l'obesità aumenta di 6 volte il rischio di ammalarsi
Set 16, 2019 12:53(Pars Today Italian) – Il fattore di rischio più pericoloso per il diabete di tipo 2 è l'obesità.
-

Occhio secco, cresce la malattia ma non è ancora riconosciuta
Set 15, 2019 13:36(Pars Today Italian) – E' una malattia e non solo un disturbo, ma ancora non e' riconosciuta come tale e spesso e' mal trattata.
-
Fda approva un farmaco per la Tbc resistente, funziona nel 90% casi
Ago 16, 2019 16:17WASHINGTON (Pars Today Italian) – Svolta nel trattamento della tubercolosi resistente agli antibiotici, un fenomeno in gravissimo e costante aumento: la Food and Drug Administration americana(Fda) ha approvato un nuovo farmaco, efficace nel 90% dei casi, quando usato in terapia combinata con altri due prodotti.
-

Oms: triplicati i casi di morbillo in tutto il mondo, oltre 360mila
Ago 13, 2019 15:24(Pars Today Italian) – Dall’1 gennaio al 31 luglio di quest’anno si sono registrati 364.808 casi di morbillo in tutto il mondo, un aumento enorme: tre volte il dato dell’anno precedente, segnalato dall’Organizzazione mondiale della sanità secondo cui nel 2018 i casi nello stesso periodo erano stati 129.239.
-

Tumore seno, nuovo test scopre le recidive in fase iniziale
Ago 09, 2019 12:12(Pars Today Italian) – Una nuova tecnologia sviluppata da ricercatori britannici e statunitensi è in grado di prevedere se persone curate per tumore al seno abbiano la probabilità di avere recidive.
-

Ematologi, grande passo avanti, ma non e' una bacchetta magica
Ago 07, 2019 15:28(Pars Today Italian) – Un "grande passo avanti per i pazienti, ma non si tratta della bacchetta magica e la cautela è sempre necessaria".
-

L'OMS contro il fumo
May 28, 2019 15:06GINEVRA (Pars Today Italian) – Torna il 31 maggio la Giornata mondiale senza tabacco, promossa dall'Organizzazione mondiale della Sanità (OMS): l'invito ai fumatori è di astenersi per almeno 24 ore dal fumo di sigarette convenzionali.
-

Oms: Algeria e Argentina libere dalla malaria
May 23, 2019 03:51(pars Today Italian) - L’Algeria, insieme all’Argentina, sono gli ultimi due Paesi in ordine di tempo che l’Organizzazione mondiale della sanità (Oms) ha dichiarato liberi dalla malaria.
-

Italia, 1°autotrapiano polmone su bimba
Mar 27, 2019 14:43GENOVA (Pars Today Italian) – Primo caso di autotrapianto polmonare su paziente pediatrico.
-

Leucemia 'sfugge' a sistema immunitario, svelato il meccanismo
Mar 27, 2019 14:08(Pars Today Italian) – Svelati i meccanismi con cui le cellule tumorali della leucemia mieloide acuta sfuggono al controllo del sistema immunitario dopo il trapianto di midollo.